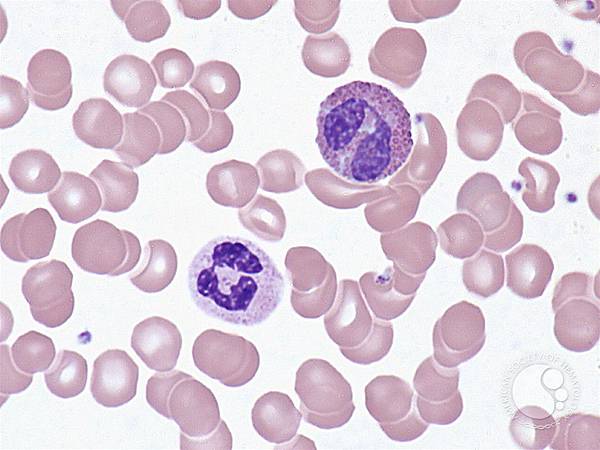
Neutrophil x Eosinophil.jfif Neutrophil x Eosinophil.jfif

傳送門:工作細胞04:食物中毒
聲明:本網站僅以教育用途而分享動畫及影片畫面,未擁有本影片之版權,也沒有營利行為。請勿任意截用圖片以作商業用途。若影片所有人要求撤除影片連結,本站即逕行撤除。
為達教育目的(如果真的有教育性的話),建議讀者先將影片看過再閱讀本文~ 無法接受對此作品評判的觀眾請儘速迴避噢(told you)
======
歡迎來到一週一回的《工作細胞》詳解!!!
這一集出現了更多值得一提的新角色,還有吼來咬去的病原體們XDD
佐以各種不明所以的奇葩劇情,快來聽聽這禮拜的劇情整理吧!!!
======
胃 Stomach


是本集被侵襲的主要器官,其實我只是想表示胃的表現超酷 岩漿超符合胃酸感的啦
更正一下上面所說的,消化系統中第一個進行消化的地方是口腔喔;口腔就會初步分解澱粉了,胃則是第一個分解蛋白質的場所
接下來,進入本集的重要角色介紹!!!
顆粒球家族 Granulocytes Family


這次終於看到顆粒球家族大團圓啦~ 今天要談的是上次的淋巴球之後,另一個重要的白血球家族,也就是
顆粒球(granulocytes),又稱為粒細胞,因為體內有「顆粒體」而得名 (granule=顆粒,-cyte=細胞)
依照瑞式染色(Wright's Stain)時吃的染劑屬性,可以分成嗜酸性、嗜中性和嗜鹼性球

其中,嗜中性球,也就是我們最常看到的男主角白血球,是體內數量最多的白血球
這集出現的嗜酸性球,主要的強項是攻擊寄生蟲;嗜鹼性球則是跟過敏反應有關係
(所以嗜中性球才說白血球的工作不只有驅除細菌而已)

顆粒性球大會師呢(由左到右依序是嗜鹼性、嗜中性、嗜酸性球)
嗜酸性球 Eosinophil

本集的主角~ 稱為嗜酸性球,或者稱為嗜酸性粒細胞/嗜酸性顆粒球
跟嗜中性球(狹義的白血球)一樣,是顆粒性球的一種。名字的eosin是指番紅伊紅(一種染劑),因為當時發現它的時候會吃伊紅故得名(8/1 13:11修正)
嗜酸性球最著名的主要功能是寄生蟲方面的免疫
不過今天額外查了資料,發現它也能調節過敏反應,還有像上次講的樹突細胞那樣,有抗原呈現的功能(但很弱)(以前都不知道,有點驚嚇)
來一張嗜酸性球的玻片照
PC:Peter Maslak
背景的芋圓東東是紅血球。嗜中性球是較下面,核長得比較碎而不規則狀(嗜中性球的特徵)
嗜酸性球則是比較上面那顆;呈現很明顯的,俗稱的「耳機狀」核~
嗜鹼性球 Basophil

那摸,再來就是第三種顆粒性球,也就是嗜鹼性球~
不同於其他的白血球,都會有攻擊抗原的能力,嗜鹼性球幾乎不會進行攻擊,而是跟過敏反應有關係

嗜鹼性球引發過敏反應後,也可以召集其他的白血球前來支援
肥大細胞 Mast Cell

既然都提到嗜鹼性球,就不得不說說肥大細胞了 (然後動畫馬上就出現了XD)
肥大細胞是嗜鹼性球之外,另一種跟過敏有關的細胞,作用也很相似
不過下一集預告就是過敏,所以到時候我們再來詳解過敏的免疫機制吧~
(坦白說這是我覺得最美的角色啊啊啊)(大心)
過敏反應跟其中抗體中的IgE 有關係,
而寄生蟲入侵會造成IgE濃度的上升,所以才會冒出這兩個角色 (雖然他們對於消滅寄生蟲沒有直接幫助啦)
而過敏會引起的發炎反應,就跟下面這款物質有關係:
組織胺 Histamine

組織胺是一種會引起發炎的物質;受傷的細胞、嗜鹼性球和肥大細胞都會分泌
組織胺可以引起微血管的通透性上升,造成腫痛,也會提高微血管的血流量,造成紅熱;
所以我們常說組織胺引起的發炎反應,叫做「紅腫熱痛」
聽起來很陌生ㄇ?其實組織胺發炎很常見,像是被蚊子叮到之後的紅紅癢癢,就是小型的組織胺發炎現象囉
講完了這集的幾個角色,再來按照劇情順序介紹其他東西
腸炎弧菌 Vibrio parahaemolyticus

首先出現的是第一批反派,也就是食物中毒中很常見的腸炎弧菌,又叫副溶血弧菌
顧名思義它就是一種弧菌(至於人設為甚麼要畫成這樣 我想完全是美術設計在爽而已XD)
是吃海鮮引起的食物中毒中,最常見的病因;引起的症狀主要也是上吐下瀉這樣子
看到這裡有點傻眼,這集連無關的輔助T細胞都來摻一腳了 (整集看起來比上一回的流感病毒混亂好多)

但在這裡說一下,食物中毒的細菌和寄生蟲,基本上是不會引起T淋巴球反應的
輔助T細胞應該也沒辦法辨認多種抗原,理應是完全派不上用場呢(傷腦筋抓抓頭)
輔助T細胞:人家只是想賺500多買幾罐介白素
吞噬作用 Phagocytosis

吞噬作用的英文 Phagocytosis,可以拆成Phago(吃)+cyto(細胞的)+sis(某某作用)
所以就是「細胞吃東西的作用」的意思
吞噬作用是白血球利用大家不陌生的一種胞器,溶體(lysosome),也就是細胞的水解酵素庫(炸彈庫) 把吃進來的細菌或是異物直接摧毀的過程

吞噬細胞有很多種,在《工作細胞》中似乎是表現成白血球們的戰鬥力
一般的吞噬作用強度是:
巨噬細胞>>嗜中性球、單核球>嗜酸性球、樹突細胞>B細胞

尷尬的就是為了配合角色的儀態,沒辦法真的做出白血球吃細菌的畫面呢XDDD
雖然有點可惜不能如實呈現 但我也不想看巨噬姊姊生吞細菌肉的畫面plz
海獸胃線蟲 Anisakis spp.

鏘鏘~本集的大反派就是 在寄生蟲學裡面蠻有名的 海獸胃線蟲~ (其實也是前陣子才在營隊剛被學長姐教過的啦XD)
海獸胃線蟲又稱為異尖線蟲,是海洋生物(魚類與海洋哺乳類)的腸胃中常見的寄生蟲
人類不是牠們生命循環中的一部分,所以被稱為牠們的「非適當宿主」
這表示海獸胃線蟲被人類不小心吞下肚子後,沒辦法發育為成蟲,但照樣會把你的肚子搞爆讓你痛不欲生

Credit:敏豪哥XD
其實想看海獸胃線蟲也不是說很困難,去魚市場買隨便一條白帶魚來,把前面1/3剖開看到腸子之後,
連腸子都不用再解剖,直接在上面把一條一條,非常非常細的小白絲抽出來,那個就是海獸胃線蟲了(茶)
沒錯~基本上你弄得到的白帶魚,有99%機會看到海獸胃線蟲噢——先不要急著罵業者無良
白帶魚被海獸胃線蟲感染的機率基本上是100%,而且這種蟲只要被妥善烹飪之後就不會對人體有害惹,魚販是冤枉的R
嘔吐 Nausea

嗜鹼性球你這個臭中二

我們來解說一下解說框裡面的一大串部位是甚麼意思:
1.我們比較常稱呼延髓為延腦,是控制身體各種反射的總指揮處;嘔吐中樞是其中一個區塊
2.胃的入口(從食道進來)稱為賁門(念成"閉門"),而胃的出口(往十二指腸)稱為幽門
3.橫膈膜其實應該稱為橫膈肌(它是肌肉噢);是把你的胸腔跟腹腔隔開的地方,也是呼吸時控制胸腔大小的重要肌肉
所以,嘔吐就是嘔吐中樞下達命令,然後把賁門跟幽門的流向弄反,然後再讓胃附近的肌肉(腹肌、橫膈肌)一起大力擠壓
然後把胃裡的東西「噗」出來(噗噗噗)
嗜酸性球的工作 Function of Eosinophil


這集來到最後,終於要讓我們的嗜酸性球凱瑞一波了!!!

這個視角超讚,好帥

很有白鯨記的感覺(原來武器拿魚叉是這個意思嗎)


喔喔喔喔喔喔喔喔

這個攻擊姿勢100分

這個落酸姿勢也100分(真美)

本集的重心落在大家對於嗜酸性球的不認識以及蔑視,後來因為表現機會出現而改變看法
基本上就是個蠻老梗的套路,甚至後面看得有點兒尷尬
畢竟對於了解嗜酸性球本領的觀眾來說,整集就只是在等寄生蟲出現讓主角來幹翻牠而已QQ
其他槽點

你們什麼時候已經進展到開頭就約會的地步了

跟工作狂交往真辛苦

(好可愛)

你們真的是同一個骨髓裡面出來的,竟然聽得懂嗎
(嗜酸性球功能+1:翻譯嗜鹼性球)

(好可愛的畫面)

這個細胞跟紅血球四處竄逃的片段 整集裡面至少用了三次

弧菌寶寶被插爽個屁(真的是爽到屁股)(哼嗯好害siu)
下圖血腥高能
赫RRRRRRRRRRRRR

乾 看了會做惡夢(表情如下圖)

結果酸民很多不是沒有原因的 連細胞都是一堆臭酸胞R
平時最愛酸,到了緊要關頭又要人家出來救

哼 一群臭酸胞
(原來嗜酸性球的意思是一直被酸)

平時被嘴翻,打贏寄蟲了才在細胞之光

其實我覺得這句非常踏實又很帥,為甚麼不給她一點發言時的效果就直接帶過去了QQ
這超偉大的啊啊啊 平時被一堆人罵翻的時候,堅持做該做的事明明就很偉大
編劇為甚麼要這樣對嗜酸性球...
(越寫越傷心)(我把相關的感想放在文末)
更多的中二劇照(果然是謎一般的細胞)

嗜鹼性球 在 胃酸雨 裡面幹古,有種莫名的詩意(???)

(好可愛)(可以去《探險活寶》應徵寄蟲公主的角色)

雖然這張圖也蠻可愛的,但我被劇情弄到非常尷尬癌,刻意過頭了(覺得全身癢)

這集用嗜鹼性球的幹言幹語作結 細胞的命運就是被身體無節制耗損跟拋棄R
======
總之以上就是這集的《工作細胞》講解~
有興趣的朋友歡迎在下方留言,歡迎更多對於講解的指教、對於影片的使用權有建議、或者提出跟動畫內容相關的問題~
下集的內容是過敏反應,再來好好介紹嗜鹼性球與肥大細胞吧(肥大細胞真的超美> <)
敬請期待,工作工作~>U<
文末難吃彩蛋
偷偷插入一下對本集的批判
純屬私人看法,對於只是想看劇情的人來說可能會不好接受,請自行參酌閱讀
第四集不管是從劇情還是知識傳遞的角度來看,都很難說是一部成功的作品,甚至接近失敗邊緣
就劇情來看,《工作細胞》固然有很多不熟諳免疫知識的觀眾,但已經知道嗜酸性球機能的觀眾同樣不在少數
如同前文所說,對於已經有先備知識的人來說,整集的感覺就只是在等大魔頭出現(還知道八成是條寄生蟲),然後讓嗜酸性球一舉解決牠,Happy Ending
而即便是「不知道嗜酸性球專殺寄生蟲」的觀眾,也能看出劇中對於此角色的性格描寫太少,卻又太過樣板,旁人對她的評論與整個劇情的走向則極度的呆板老套
也許嗜酸性球的人設看起來沒有血小板或巨噬細胞那麼亮眼,但這集/這個角色會不如前兩集吸引人的地方,恐怕劇情才是更大的敗筆
坦白說,我聽到對於嗜鹼性球的中二表現的討論度,竟然比嗜酸性球這個主角還要高,可見這個角色的塑造的確有點失敗了
彷彿編劇用了整集想要營造出一個努力不被人討厭的角色,卻讓這個角色很難被討論和喜歡
又從知識傳遞的角度來看,這一集其實出現了很多可以解說的東西
例如嗜鹼性球跟肥大細胞之所以會亮相,是因為寄蟲造成IgE濃度上升,因此才會有過敏細胞的介入;但組織胺的作用完全沒有表現,就只是像灑水器一樣的串場(可能是要留到下一集的過敏主題講)
而輔助T細胞的極短現身(用意不明)、延腦裡面食物中毒時的螢幕畫面,也都沒有更多的說明;再加上滿滿的「好大的晃動」「這是怎麼回事」
種種情節雖然都是要鋪陳海獸胃線蟲的出現,卻只讓人看得一頭霧水。丟出各種新角色、新物質卻也沒有充分講解其功能,竊以為本集並沒有達到《工作細胞》身為「知識番」的功用
即便如此,本集的美術水準至少沒有掉。但劇情走向與知識傳遞,就真的雙雙可惜了 (也許是上一集做得太好也說不定啦)
其實嗜酸性球還有抗原呈現的功能;如果給她一部對講機,帥氣的跟樹突細胞聯絡肯定也是不錯的
此外,還可以調節超多種免疫細胞(嗜中性球、嗜鹼性球、肥大細胞、樹突細胞、輔助T細胞、B細胞),基本上這個角色一點都不無聊呀!!!
連超複雜的凝血機轉都可以做成萌萌的血小板了,真希望劇組當初可以在嗜酸性球身上下更多功夫做人設呀QQ
以上純屬個人抱怨,放在文末雖然有點怪,但實在不想影響讀者的閱讀體驗... 只好把醜話放後頭囉
相信下一集還是值得期待的!!! (也請看到這裡的讀者朋友們繼續支持本系列!!!)
請先 登入 以發表留言。